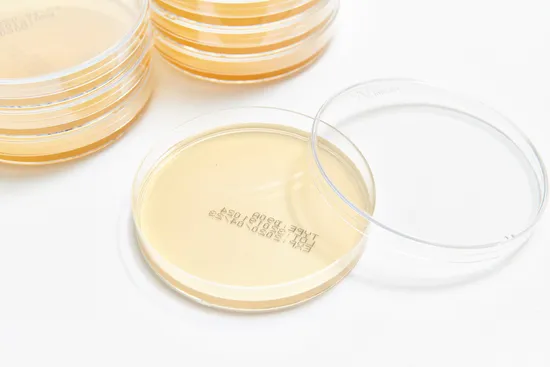

|
US$0.30-3.00
|
100 PCS
(MOQ)
|
Basic Info.
Ethylene Oxide Sterilization
Irradiation Sterilization
Quality Guarantee Period
6 Months
Logo Printing
Accept Customization
Finished Dosage Form
Liquid
Computerized
Accept Computerized
After-Sales Service
Enginners Available to Serve Machinery on Line
Specification
1450*610*1500mm
Production Capacity
1000000000
Product Description
Detailed Product Description
| products appearance | Light yellow, flat surface, no cracks, no visible impurities and bubbles |
| physicochemical property | PH acceptable, gel strength 500-750g/cm2 |
| Sterility and water retention | 30-35ºC,Culture for 5 days, no bacterial growth,Culture for 5 days, no bacterial growth, no obvious water loss phenomenon |
| Packing | Class A laminar flow production line automatic canning, to avoid the risk of personnel pollution |
| Growth experiment | Inoculate the corresponding strains 50-100CFU according to the pharmacopoeia, and the ratio of the mean number of colonies on the test solid medium to the mean number of colonies on the control medium should be within the range of 0.5-2, and the size of the colonies should be consistent with the colonies on the control medium |
parameter
| Products code | Item | Discreption | Usage |
| CP020028 | D55A | | |
| CPO20029 | D90A | | |
| | | | |
| | | | |
| | | | |
| | | | |
| | | | |
| | | | |
| | | | |
| | | | |
| | | | |
| | | | |
The collection collection incubator is carefully manufactured by forty processes, each in strict accordance with the ISO9001 quality system and ISO14001 environmental system requirements. 100% of the products passed the integrity test, achieving continuous improvement in quality traceability and quality. According to the testing requirements of different dosage forms and packaging forms, various cups, filter materials and matching needles were selected, and various collection incubators were designed and developed to meet various sterilization tests. need.
Product rinse sterility test
Combination product: Product rinse sterility test is only applicable to products with hollow tubes, such as infusion and infusion sets, which are not suitable for soaking and the fluid channel is marked as sterile, this method is easy to operate and requires modification of FTM media with liquid D rinse products, The eluate was membrane filtered and placed in FTM and SCDM. This method is usually not used.
Bulk drugs / biopharmaceuticals
Bulk drugs (API) have been sterilised according to USP 71 prior to release to the manufacturing process.
Bulk biologics are tested for sterility according to 21 CFR 610.12, which requires a medium (FTM) with sample test sizes listed in the document and a capacity of not less than 10 ml.10
Interpretation of sterility test results
Technicians must be trained in growth testing methods during the cultivation process. Growth is determined by observing a medium that is generally transparent and transparent with respect to the light source, and the turbid (turbid) area of the medium indicates the growth of microorganisms. Once growth is detected, the suspect container is tested to confirm that the turbidity present is due to microbes, not due to decomposition of the sample; sometimes, the sample becomes cloudy due to particle shedding or chemical reaction with the medium. After testing, return to the incubator for the remainder of the incubation period. Samples turbid in the medium were transferred and displayed for four days on the 14th day of the test. Tag: Laboratory Petri Dish Cell Culture Dish bulkbuy
Petri Dish Products
Plastic Petri Dish
>>
Bamboo wooden Salt Spice Jar Salt Shaker mixing bowl With Lid And Spoon
>>
Professional 18" Strong Magnets Knife Strip Stainless Steel Knife Magnetic Rack
>>
High-Tech Advanced Disc Centrifuge for Separating Animal Cottonseed Vegetable Oil on Sales
>>
Hand Blown Glass Automatic Potted Plant/Flower Watering System Drip Irrigation Device Dripper Planter
>>
New Product Lace Bodysuit Built in Bra Shapewear Bodysuit Tops for Women Plunge Deep V Neck Body Suits Backless Tummy Control Going Out
>>
M 7-Inch WiFi Audio Power Amplifier 8*25 W 4-8 Ohm 8-CH Blue-Tooth Wall Amplifier for Homes or Commercial
>>
Waste Tire Plastic To Oil Pyrolysis Plant Batch Continuous type - 1TPD to 50 TPD
>>
Branded Pharmacy Advertising Merchandise Items for Business Gifts
>>
11-150kw Commercial Heat Pump Water Heater High Cop with Copeland Compressor
>>
7g Credit Card Mints Xylitol Candy Cool Fresh Mints for Promotion Gift
>>
Good Quality Multistage Corrosion Wear Resistance Stainless Steel Booster Pump for Mill Industry
>>
good material electric powered stair climbing hand truck stair climber
>>
Green-Tec energy-saving furnace to carbonize coconut shell,wood log,sawdust
>>
Oil Seal Skeleton Rubber Oil Seal with NBR FKM Thread Oil Seal Widely Use 50-70-10 100-125-15
>>
Commercial Cardio Training LED Screen Running Fitness Equipment Motorized Electric Treadmill
>>
Enzolo Motorcycle Parts Motorcycle Brake Shoes for YAMAHA Fz 16
>>
Portable Blender, Personal Size Blender Juicer Cup, Smoothies
>>
Pressurized Blowback Hot Gas Filter
>>
Saving Energy Pco1810 Mineral Water Cooking Oil Bottle Pet Preform Jar Servo Injection Molding Machine
>>
3kw New UHF Four-Dipole TV Transmission Antenna